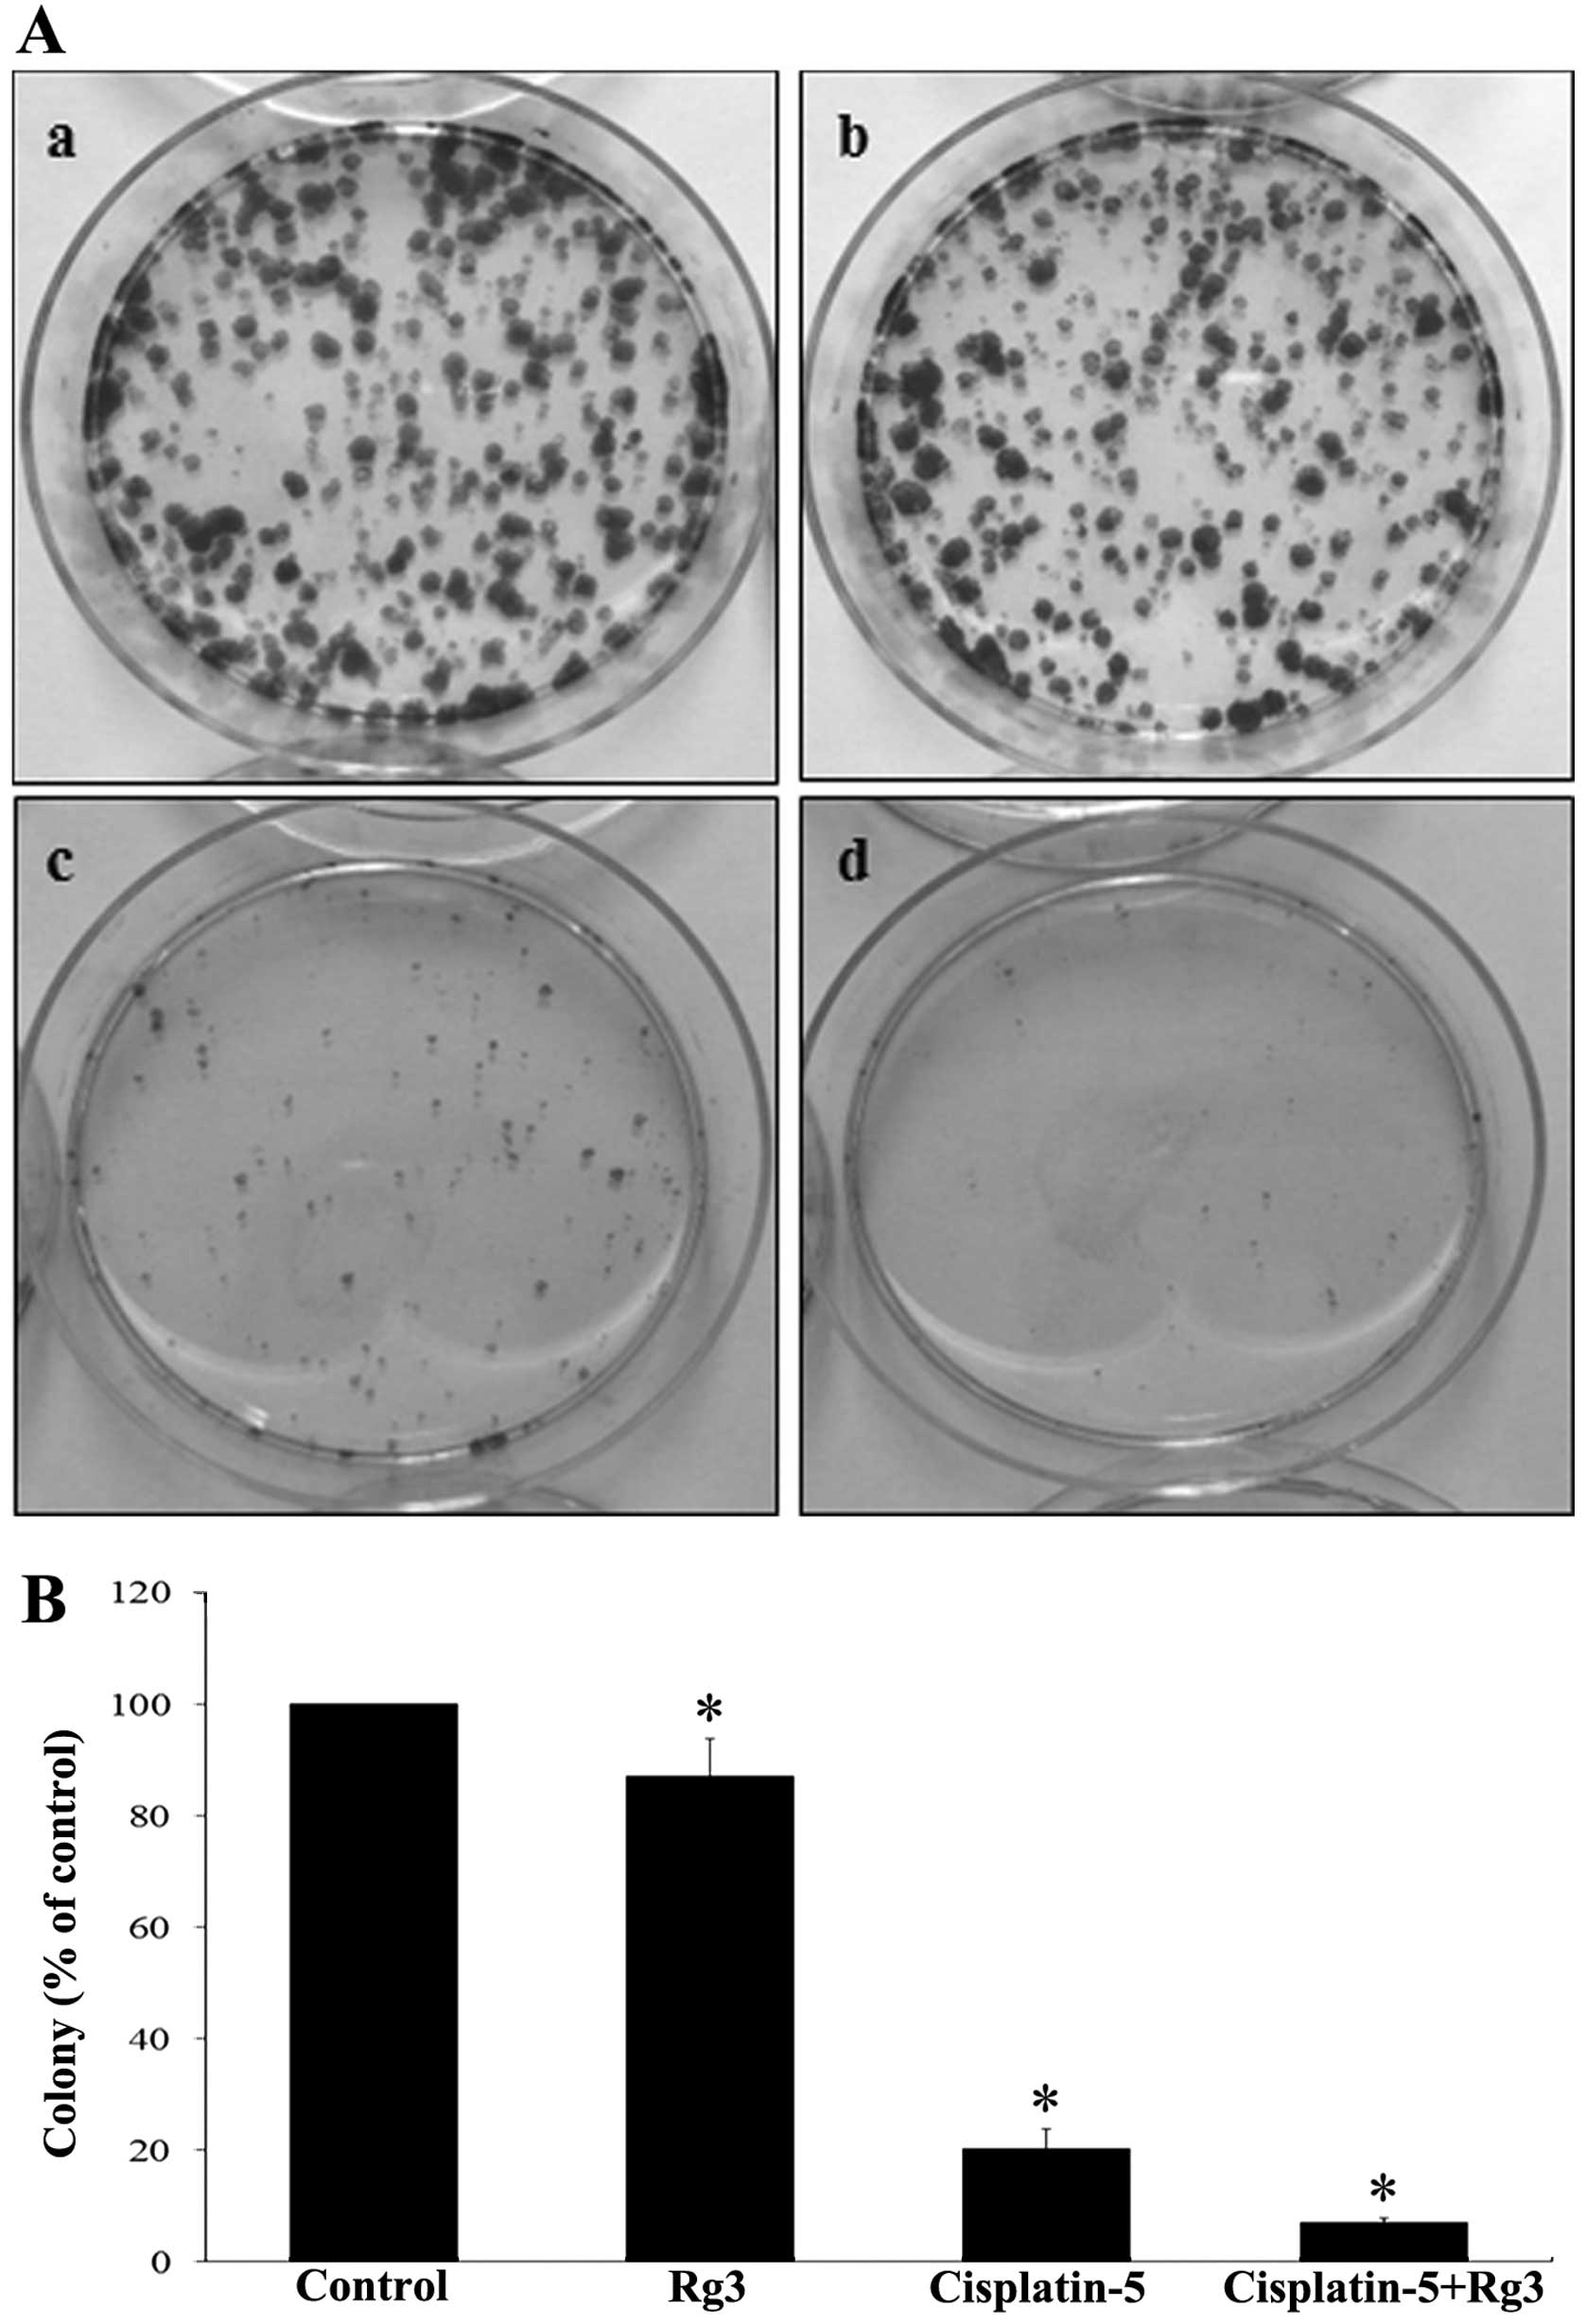

Introduction
Cisplatin-based chemotherapy remains the first-line
treatment of metastatic urothelial or transitional cell carcinoma.
However, advanced age, poor performance status and renal
dysfunction often preclude it. As no standard regimen has been
established for patients who relapse after first-line
cisplatin-based chemotherapy, it is essential to establish an
effective chemotherapy regimen for patients with
cisplatin-resistant bladder cancer. Taxane-based salvage
chemotherapy and novel chemotherapeutic agents may be used for
patients with cisplatin-resistant diseases. Numerous agents are
under investigation or being tested in clinical trials to identify
a novel tolerable target agent (1).
However, the outcomes thus far are unsatisfactory.
Ginseng has been used in Asia as a medicinal plant
to treat various diseases. Ginsenoside is an active compound of
ginseng. Ginsenoside Rg3 is a natural product isolated from Panax
ginseng. It induces apoptosis in human glioblastoma cell lines
(2) and has an antitumor effect on
hepatocellular carcinoma cells via the intrinsic apoptotic pathway
(3–5).
In the present study, we investigated the antitumor
effect of ginsenoside Rg3 and its synergism with cisplatin in
cisplatin-resistant bladder tumor cells.
Materials and methods
Cell lines and chemicals
Bladder cancer cells (HTB5, J82, JON, UMUC14 and
T24) were obtained from ATCC (Manassas, VA, USA). T24R2
cisplatin-resistant bladder cancer cells were generated by serial
desensitization (6). The cells were
maintained in RPMI (T24, T24R2), Dulbecco’s modified Eagle’s medium
(J82, UMUC14) and modified Eagles’ medium (HTB5) supplemented with
10% fetal bovine serum (Mediatech, Herndon, VA, USA) and 100 U/ml
penicillin/100 mg/l of streptomycin (Invitrogen, Carlsbad, CA,
USA). Cisplatin was obtained from Pfizer Korea Ltd., Seoul, Korea.
Ginsenoside Rg3 was obtained from Sigma-Aldrich Corporation (St.
Louis, MO, USA).
Cell proliferation assay
Bladder cancer cells were plated in 96-well plates
and treated with cisplatin (0–20 μg/ml) and ginsenoside Rg3 (0–50
μM) for 48 h. At the end of drug exposure, 10 μl of the Cell
Counting Kit-8 solution (Dojindo Molecular Technologies,
Gaithersburg, MD, USA) was added to each well containing 100 μl of
medium. After 4 h of incubation, absorbance at 450 nm was
measured.
Determination of synergism
The synergism between the two drugs was determined
according to the combination index using CalcuSyn, version 2.1
(Biosoft, Cambridge, UK) (7). CI
values of <1.0, 1.0 and >1.0 indicated synergism, additive
effect and antagonism, respectively (8).
Clonogenic assay
For the colony-forming assay, T24R2 cells were
treated with cisplatin (5.0 μg/ml) and/or ginsenoside Rg3 (50 μM)
for 48 h and maintained in a drug-free medium for an additional 2
weeks. After staining with the 0.4% crystal violet, the number of
colonies >0.2 mm in diameter was counted.
Cell cycle analysis by flow
cytometry
T24R2 cells were treated with cisplatin (5 μg/ml)
and/or ginsenoside Rg3 (50 μM) for 48 h, and flow cytometric
analyses were conducted as previously described (9). The cell cycle distribution was
determined by FACSCalibur™ flow cytometer (BD Biosciences, Franklin
Lakes, NJ, USA).
Western blot analysis
After the 48-h of treatment of T24R2 cells with
cisplatin (5.0 μg/ml) and/or ginsenoside Rg3 (50 μM), proteins were
extracted using RIPA lysis buffer and Mitochondrial Isolation kit
(Thermo Scientific, Rockford, IL, USA). Electrophoresis was
performed using sodium dodecyl sulfate-polyacrylamide gel. The
proteins were transferred with polyvinylidene fluoride membranes
(Millipore, Billerica, MA, USA) and blocked for 1 h with
Tris-buffered saline-Tween containing 5% milk. Primary antibodies
to caspase-3, -8 and -9, full length PARP, fragmented PARP, cyclin
A, B1 and D1, cytochrome c, p21, Bcl-2 and Bad were
incubated overnight at 4°C.
Statistical analysis
Unless otherwise specified, the results are
expressed as the means ± SD after a minimum of three repeated
experiments. Tukey’s multiple range tests were used to assess the
statistical significance. P<0.05 was considered to indicate a
statistically significant result. All the analyses were conducted
using IBM SPSS version 21.0 (SPSS Inc., Chicago, IL, USA).
Results
Antitumor effect of cisplatin and
ginsenoside Rg3 on bladder cancer cell lines
Cisplatin exerted an antitumor effect on bladder
tumor cells. The viability of HTB5, J82, JON and UMUC14 cells was
decreased after cisplatin treatment in a dose-dependent manner.
However, ginsenoside Rg3 did not affect cell viability at any dose,
regardless of the presence of cisplatin (Fig. 1).
In contrast to that of the HTB5, J82, JON and UMUC14
bladder tumor cells, the viability of T24R2 cells was not affected
by the cisplatin dose up to the concentration of 2.0 μg/ml, as
shown in a previous study (10).
However, at a dose of >2.0 μg/ml of cisplatin, T24R2 cell
viability was reduced according to the incremental dose of
cisplatin (Fig. 2). The addition of
ginsenoside Rg3 reduced T24R2 cell viability at any cisplatin dose.
The antitumor effect was most prominent at the dose of 50 μM of
ginsenoside Rg3. Synergism was evident when concentrations of
cisplatin were <2.0 μg/ml, where T24R2 cell viability was
significantly reduced according to the increase of the cisplatin
dose. The combination index of cisplatin and 50 μM of ginsenoside
Rg3 after 48 h of exposure was <1.0, showing the synergism
between the two agents (Fig. 2B).
The IC50 value of ginsenoside Rg3 in T24R2 cells after
48 h of exposure was 207.7 μg/ml.
Ginsenoside Rg3 mediated T24R2 cell
resensitization
A clonogenic assay was performed to evaluate the
cytotoxic effect of cisplatin and ginsenoside Rg3. T24R2 cells were
treated with cisplatin (5 μg/ml) and/or ginsenoside Rg3 (50 μM) for
48 h and the results of subsequent staining are shown in Fig. 3. The treatment of cisplatin reduced
the number of colonies significantly and the inhibitory effect was
greatest after the combined treatment of cisplatin and ginsenoside
Rg3.
Ginsenoside Rg3 potentiates
cisplatin-induced cell cycle alterations
A flow cytometric analysis was performed to
investigate the effect of ginsenoside Rg3 on cell cycle
progression. Cell cycle arrest was observed at the G2/M phase after
the treatment of cisplatin (Fig.
4). The combined treatment of cisplatin and ginsenoside Rg3
enhanced cisplatin-induced cell cycle alterations, although the
result was not statistically significant. When T24R2 cells were
treated with 10 μg/ml of cisplatin with ginsenoside Rg3, the
distribution of the cell cycle was shifted towards the S phase,
showing the cell cycle alteration by ginsenoside Rg3 (data not
shown).
Ginsenoside Rg3 and changes of apoptosis
and cell cycle regulator expression
Western blotting was performed to investigate the
underlying mechanism of cell cycle regulation. Cleaved PARP,
caspase-3, -8 and -9 (Fig. 5) and
cytochrome c (Fig. 6) were
increased significantly after the treatment of cisplatin. The
increase was enhanced following the combined treatment. The
expression of full-length PARP was decreased following the
treatment of cisplatin and the combined treatment. Bcl-2 expression
was decreased, whereas the activity of Bad was increased following
the combined treatment of cisplatin and ginsenoside Rg3 (Fig. 6). Thus, activation of the intrinsic
apoptotic pathway was associated with the synergism of these
agents.
Cyclin B1 expression was significantly increased
after the treatment with cisplatin and it was further enhanced
following the combined treatment. The expression of other cyclins
such as cyclin A and D1 was not identified by western blotting
(data not shown). The increase of cyclin B1 after the combined
treatment was correlated with the result of cell cycle alterations,
suggesting the cell cycle arrest at the G2/M phase.
Discussion
Cisplatin is a platinum-based DNA alkylating agent
that induces DNA damage, cell cycle arrest at G2/M phase, and
apoptosis (11). Cisplatin-based
combination chemotherapy has been the standard treatment method of
advanced bladder cancer since the late 1980s (12–15).
For patients with cisplatin-resistant bladder cancer, second-line
treatment remains to be determined and many drugs are under
investigation or being tested in clinical trials. The results of
the present study have shown that ginsenoside Rg3 inhibits the
growth of T24R2 cells in a synergistic manner with cisplatin. No
synergism was observed between cisplatin and ginsenoside Rg3 when
other cisplatin sensitive bladder cancer cell lines were treated
alone or in combination. The survival of those cells was affected
by cisplatin.
The chemosensitization of ginsenoside Rg3 has been
previously reported. Kim et al reported that for prostate
cancer, ginsenoside Rg3 enhanced the chemosensitivity of prostate
cancer cells for docetaxel by the inhibition of NF-κB (16). They also demonstrated that the
combined treatment of ginsenoside Rg3 with cisplatin inhibited the
growth of prostate cancer cells more than either of the single
regimen treatments. Lee et al reported that for colon
cancer, ginsenoside Rg3 enhanced the chemosensitivity of tumors for
cisplatin in vivo, using a murine xenograft model with CT-26
colon carcinoma cells (17). The
results of the present study are in concordance with the results of
those studies.
There are two possible explanations for the
abovementioned results. First, the result suggests that the impact
of ginsenoside Rg3 was not sufficiently strong to surpass the
effect of cisplatin in cisplatin-sensitive cells. By contrast, when
it was combined with cisplatin, the cell cycle arrest of the G2/M
phase was potentiated with ginsenoside Rg3, which may contribute to
the cell cycle arrest at the G1/S phase, consolidating the cell
cycle alterations. The optimum concentration at which the antitumor
effect was evident was <2.0 μg/ml of cisplatin. Second, since
cisplatin-resistant bladder cancer cells have an increased
expression of Bcl-2 (10), the
inhibition of Bcl-2 following the treatment of ginsenoside Rg3 may
lead to the more potent inhibition of viability in those cells.
Although the underlying mechanism of cell cycle
regulation was not examined in the present study, the change of
p21, which occurred only after the combined treatment, may be
important in the synergism between the two agents. The combined
treatment of ginsenoside Rg3 enhanced the cell cycle arrest at the
G1/S checkpoint with the induction of p21, leading to a synergistic
antitumor effect. However, irrespective of whether ginsenoside Rg3
was treated alone, alterations in the cell cycle may not have been
sufficiently strong to induce the antitumor effect.
Cyclin B1 is expressed predominantly during the G2/M
phase of the cell cycle (18), and
its increased expression is correlated with the result of flow
cytometry. Chen et al have shown that ginsenoside Rg3
inhibited the proliferation of EJ cells in bladder cancer cells by
inducing apoptosis (19). The
proportion of the S and G2/M phase was increased, while that of the
G0-G1 transition was decreased in the cell cycle analysis, which
was in agreement with our results. In addition, the increase of p21
only after the combined treatment may contribute to the cell cycle
alteration, resulting in synergism.
Bcl-2 protein is an integral outer mitochondrial
membrane protein that blocks the apoptotic death of some cells. Our
results showed that the combined treatment of ginsenoside Rg3 and
cisplatin was associated with the reduced level of expression in
Bcl-2. Duggan et al showed that the downregulation of Bcl-2
protein enhanced mitomycin C induced apoptotic cell death in
bladder cancer (20), although the
prognostic significance of those findings was not consistent in the
literature (21–24). Bolenz et al also demonstrated
that the addition of Bcl-2 antisense oligodeoxynucleotides enhanced
the cytotoxic potential of cisplatin as well as other
chemotherapeutic agents such as mitomycin C in transitional
carcinoma cell lines (25). Hong
et al demonstrated that the expression of Bcl-2 mRNA and
protein was increased in cisplatin-resistant bladder cancer cells
and treatment with antisense Bcl-2 oligonucleotide enhanced the
cytotoxicity of cisplatin significantly (10). Those results may have an impact on
results of this study.
In addition to the suppression of Bcl-2, western
blotting showed increased activity of proteins including cytochrome
c and caspase-3, which was known to be involved in the
intrinsic apoptotic pathway. Jiang et al demonstrated that
ginsenoside Rg3 alone or the combined treatment with
chemotherapeutic agents inhibited tumor growth in hepatocellular
carcinoma via the activation of an intrinsic apoptotic pathway
through alterations in the expression of Bcl-2 family proteins
(4), which was in concordance with
our result.
Bad is a pro-apoptotic protein and known to
interfere the anti-apoptotic function of Bcl-2 and Bcl-xL in
mitochondria (26). The increase of
Bad and the decrease of Bcl-2 with the simultaneous increase of
cytochrome c after the combined treatment of ginsenoside Rg3
and cisplatin suggests that the activation of the intrinsic
apoptotic pathway is involved in the underlying mechanism.
In conclusion, ginsenoside Rg3, when combined with
cisplatin, synergistically inhibits the growth of
cisplatin-resistant bladder cancer cells. The enhancement of cell
cycle alterations and activation of the intrinsic apoptotic pathway
may be a possible underlying mechanism.
Acknowledgements
This study was funded by the Research Fund at Seoul
National University Bundang Hospital (grant no. 02-2013-096), and a
research grant from Handok Inc.
References
|
1
|
Ortmann CA and Mazhar D: Second-line
systemic therapy for metastatic urothelial carcinoma of the
bladder. Future Oncol. 9:1637–1651. 2013. View Article : Google Scholar : PubMed/NCBI
|
|
2
|
Choi YJ, Lee HJ, Kang DW, Han IH, Choi BK
and Cho WH: Ginsenoside Rg3 induces apoptosis in the U87MG human
glioblastoma cell line through the MEK signaling pathway and
reactive oxygen species. Oncol Rep. 30:1362–1370. 2013.PubMed/NCBI
|
|
3
|
Park HM, Kim SJ, Kim JS and Kang HS:
Reactive oxygen species mediated ginsenoside Rg3- and Rh2-induced
apoptosis in hepatoma cells through mitochondrial signaling
pathways. Food Chem Toxicol. 50:2736–2741. 2012. View Article : Google Scholar
|
|
4
|
Jiang JW, Chen XM, Chen XH and Zheng SS:
Ginsenoside Rg3 inhibit hepatocellular carcinoma growth via
intrinsic apoptotic pathway. World J Gastroenterol. 17:3605–3613.
2011. View Article : Google Scholar : PubMed/NCBI
|
|
5
|
Zhang C, Liu L, Yu Y, Chen B, Tang C and
Li X: Antitumor effects of ginsenoside Rg3 on human hepatocellular
carcinoma cells. Mol Med Rep. 5:1295–1298. 2012.PubMed/NCBI
|
|
6
|
Byun SS, Kim SW, Choi H, Lee C and Lee E:
Augmentation of cisplatin sensitivity in cisplatin-resistant human
bladder cancer cells by modulating glutathione concentrations and
glutathione-related enzyme activities. BJU Int. 95:1086–1090. 2005.
View Article : Google Scholar
|
|
7
|
Chou TC and Talalay P: Quantitative
analysis of dose-effect relationships: the combined effects of
multiple drugs or enzyme inhibitors. Adv Enzyme Regul. 22:27–55.
1984. View Article : Google Scholar
|
|
8
|
Chou TC, Motzer RJ, Tong Y and Bosl GJ:
Computerized quantitation of synergism and antagonism of taxol,
topotecan, and cisplatin against human teratocarcinoma cell growth:
a rational approach to clinical protocol design. J Natl Cancer
Inst. 86:1517–1524. 1994. View Article : Google Scholar
|
|
9
|
Yoon CY, Park MJ, Lee JS, et al: The
histone deacetylase inhibitor trichostatin A synergistically
resensitizes a cisplatin resistant human bladder cancer cell line.
J Urol. 185:1102–1111. 2011. View Article : Google Scholar : PubMed/NCBI
|
|
10
|
Hong JH, Lee E, Hong J, Shin YJ and Ahn H:
Antisense Bcl2 oligonucleotide in cisplatin-resistant bladder
cancer cell lines. BJU Int. 90:113–117. 2002. View Article : Google Scholar : PubMed/NCBI
|
|
11
|
Sorenson CM, Barry MA and Eastman A:
Analysis of events associated with cell cycle arrest at
G2 phase and cell death induced by cisplatin. J Natl
Cancer Inst. 82:749–755. 1990. View Article : Google Scholar : PubMed/NCBI
|
|
12
|
von der Maase H, Hansen SW, Roberts JT, et
al: Gemcitabine and cisplatin versus methotrexate, vinblastine,
doxorubicin, and cisplatin in advanced or metastatic bladder
cancer: results of a large, randomized, multinational, multicenter,
phase III study. J Clin Oncol. 18:3068–3077. 2000.
|
|
13
|
Loehrer PJ Sr, Einhorn LH, Elson PJ, et
al: A randomized comparison of cisplatin alone or in combination
with methotrexate, vinblastine, and doxorubicin in patients with
metastatic urothelial carcinoma: a cooperative group study. J Clin
Oncol. 10:1066–1073. 1992.
|
|
14
|
Logothetis CJ, Dexeus FH, Finn L, et al: A
prospective randomized trial comparing MVAC and CISCA chemotherapy
for patients with metastatic urothelial tumors. J Clin Oncol.
8:1050–1055. 1990.PubMed/NCBI
|
|
15
|
Sternberg CN, Yagoda A, Scher HI, et al:
Preliminary results of M-VAC (methotrexate, vinblastine,
doxorubicin and cisplatin) for transitional cell carcinoma of the
urothelium. J Urol. 133:403–407. 1985.PubMed/NCBI
|
|
16
|
Kim SM, Lee SY, Cho JS, et al: Combination
of ginsenoside Rg3 with docetaxel enhances the susceptibility of
prostate cancer cells via inhibition of NF-κB. Eur J Pharmacol.
631:1–9. 2010.PubMed/NCBI
|
|
17
|
Lee CK, Park KK, Chung AS and Chung WY:
Ginsenoside Rg3 enhances the chemosensitivity of tumors to
cisplatin by reducing the basal level of nuclear factor erythroid
2-related factor 2-mediated heme oxygenase-1/NAD(P)H quinone
oxidoreductase-1 and prevents normal tissue damage by scavenging
cisplatin-induced intracellular reactive oxygen species. Food Chem
Toxicol. 50:2565–2574. 2012.
|
|
18
|
Entrez Gene. CCNB1 cyclin B1. Accessed
January 15, 2014
|
|
19
|
Chen JX, Peng HM, Pu SP and Guo YP:
Inducement effect of ginsenoside Rg3 on apoptosis of human bladder
transitional cell carcinoma cell line EJ. Zhongguo Zhong Yao Za
Zhi. 32:1680–1684. 2007.(In Chinese).
|
|
20
|
Duggan BJ, Maxwell P, Kelly JD, et al: The
effect of antisense Bcl-2 oligonucleotides on Bcl-2 protein
expression and apoptosis in human bladder transitional cell
carcinoma. J Urol. 166:1098–1105. 2001. View Article : Google Scholar : PubMed/NCBI
|
|
21
|
Touloupidis S, Fatles G, Kalaitzis C, et
al: The significance of p53 and bcl-2 overexpression and other
prognostic factors in transitional cell carcinoma of the bladder.
Int Urol Nephrol. 38:231–236. 2006. View Article : Google Scholar : PubMed/NCBI
|
|
22
|
Glick SH, Howell LP and White RW:
Relationship of p53 and bcl-2 to prognosis in muscle-invasive
transitional cell carcinoma of the bladder. J Urol. 155:1754–1757.
1996. View Article : Google Scholar : PubMed/NCBI
|
|
23
|
Wu TT, Chen JH, Lee YH and Huang JK: The
role of bcl-2, p53, and ki-67 index in predicting tumor recurrence
for low grade superficial transitional cell bladder carcinoma. J
Urol. 163:758–760. 2000. View Article : Google Scholar : PubMed/NCBI
|
|
24
|
Uchida T, Minei S, Gao JP, Wang C, Satoh T
and Baba S: Clinical significance of p53, MDM2 and bcl-2 expression
in transitional cell carcinoma of the bladder. Oncol Rep.
9:253–259. 2002.PubMed/NCBI
|
|
25
|
Bolenz C, Becker A, Trojan L, et al:
Optimizing chemotherapy for transitional cell carcinoma by
application of bcl-2 and bcl-xL antisense oligodeoxynucleotides.
Urol Oncol. 25:476–482. 2007. View Article : Google Scholar : PubMed/NCBI
|
|
26
|
Le Bras M, Rouy I and Brenner C: The
modulation of inter-organelle cross-talk to control apoptosis. Med
Chem. 2:1–12. 2006.PubMed/NCBI
|